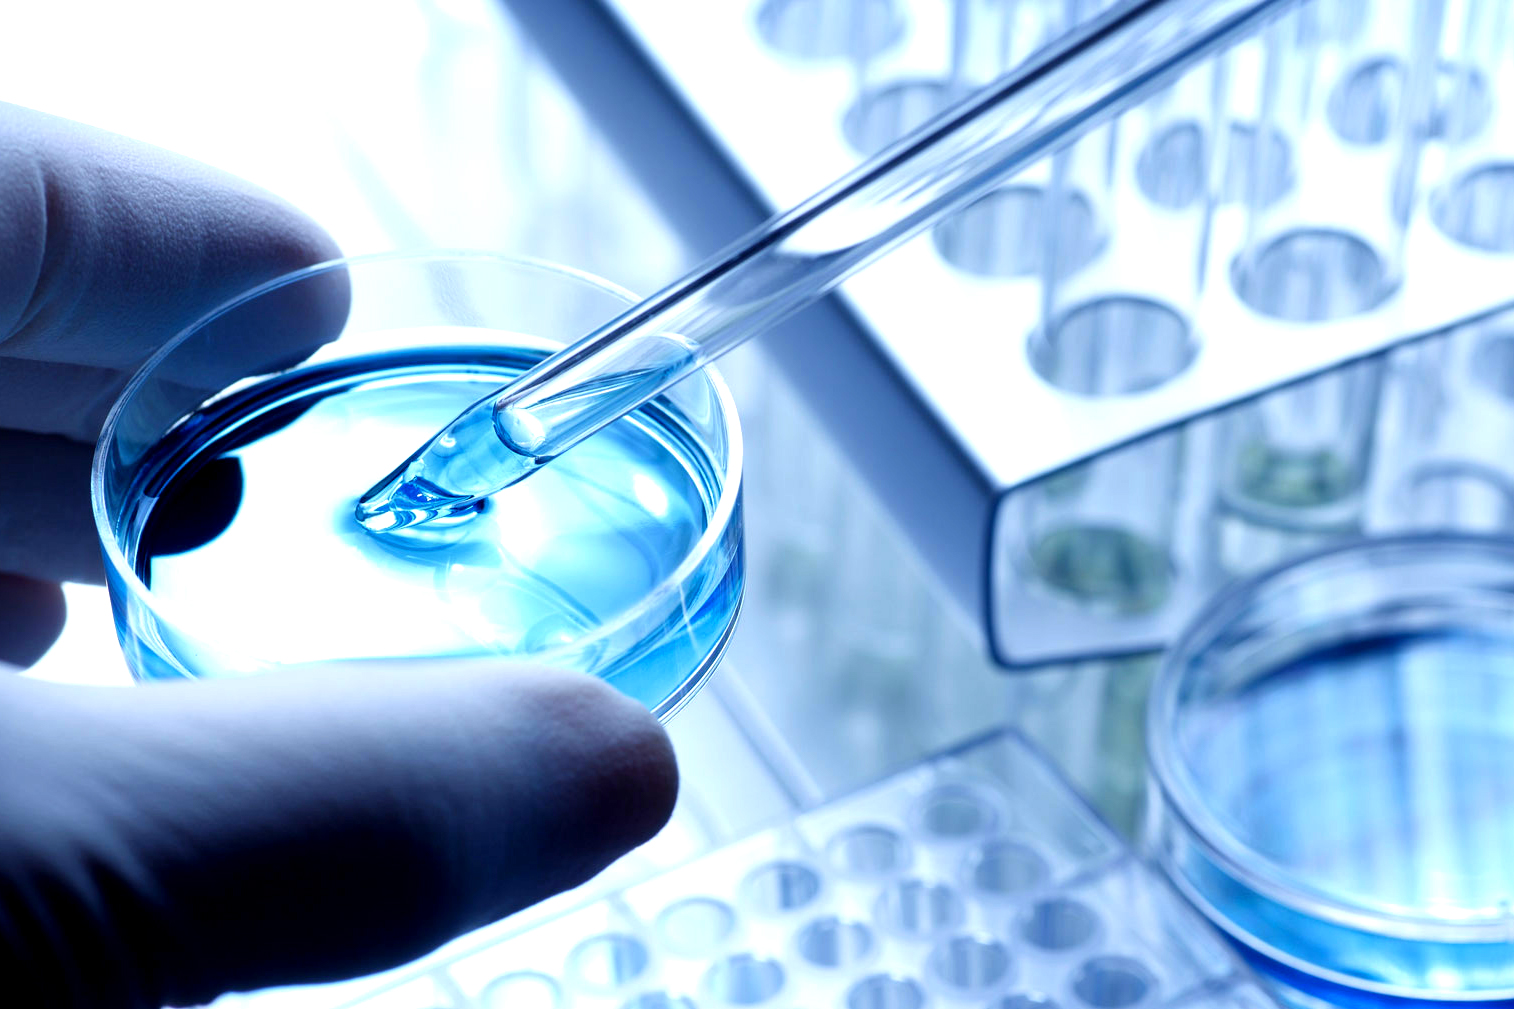

Un lungo lavoro preparatorio che premia: arriva il patteggiamento
Non è stata una semplice attività di difesa nel senso di contestazione delle ipotesi accusatorie, ma un lavoro complesso ed esteso su più fronti, quello

Non è stata una semplice attività di difesa nel senso di contestazione delle ipotesi accusatorie, ma un lavoro complesso ed esteso su più fronti, quello

E’ stato riconosciuto che sono vittime di un reato, è stato riconosciuto il loro diritto a un risarcimento, pagato, ma il problema non si risolve.

Una assoluzione alla quale ha contribuito in maniera determinante l’avvocato Marco Casellato di Rovigo, componente della rete professionale Lpteam, quella di due parroci del circondario

Testimonianze importanti sono state rese nelle udienze del 21 e del 28 aprile del processo ambientale in corso di fronte alla Corte di Assise a

Nel maxi processo aperto di fronte alla Corte di Assise di Vicenza sul caso Pfas, che vede impegnati, come parte civile, gli avvocati della rete

Altri due importanti processi, uno ambientale e uno relativo a omicidio colposo plurimo e violazioni della sicurezza sul lavoro, che vedeva vari avvocati della rete

Va esclusa la legittimazione passiva della società Mandataria del raggruppamento temporaneo di imprese (RTI) per il debito assunto da una delle società Mandanti del raggruppamento

E’ stata una udienza di grande importanza, quella dello scorso 18 gennaio, in tribunale a Savona, dove è aperto, di fronte al giudice monocratico, il
La criticità della contaminazione da Pfas della falda acquifera, nel Comune di Trissino, nel Vicentino – problematica che poi si è estesa, purtroppo, ben oltre

Il ricorso straordinario al presidente della Repubblica è stato trasposto in un procedimento avanti al Tar di Venezia: sarà, quindi, in questa sede che verrà
MGTM AVVOCATI ASSOCIATI
CORSO GIOVECCA, 3 – 44121 FERRARA
SEGRETERIA@MGTM.IT
TEL: 0532 203388
P.IVA 01434380380
POLIZZA RC PROFESSIONALE GROUPAMA ASSICURAZIONI SPA N. 1101693
MASSIMALE € 1.500.000
GBMR LEGAL NETWORK
VIA TOMMASEO 69/D – 35131 PADOVA
STUDIO@GBMR.IT
TEL: 049 8072835
P.IVA 03462690284
POLIZZA RC GENERALI SPA N. 301432233
MASSIMALE € 516.000, SECONDO RISCHIO € 700.000
STUDIO LEGALE MATTEO CERUTI
VIA ALL’ARA, 8 – 45100 ROVIGO
MATTEO.CERUTI@LIBERO.IT
P.IVA 01075120293
POLIZZA ITAS ASSICURAZIONI N. 6Z/M12175616
MASSIMALE € 2.000.000
To provide the best experiences, we and our partners use technologies like cookies to store and/or access device information. Consenting to these technologies will allow us and our partners to process personal data such as browsing behavior or unique IDs on this site and show (non-) personalized ads. Not consenting or withdrawing consent, may adversely affect certain features and functions.
Click below to consent to the above or make granular choices. Your choices will be applied to this site only. You can change your settings at any time, including withdrawing your consent, by using the toggles on the Cookie Policy, or by clicking on the manage consent button at the bottom of the screen.